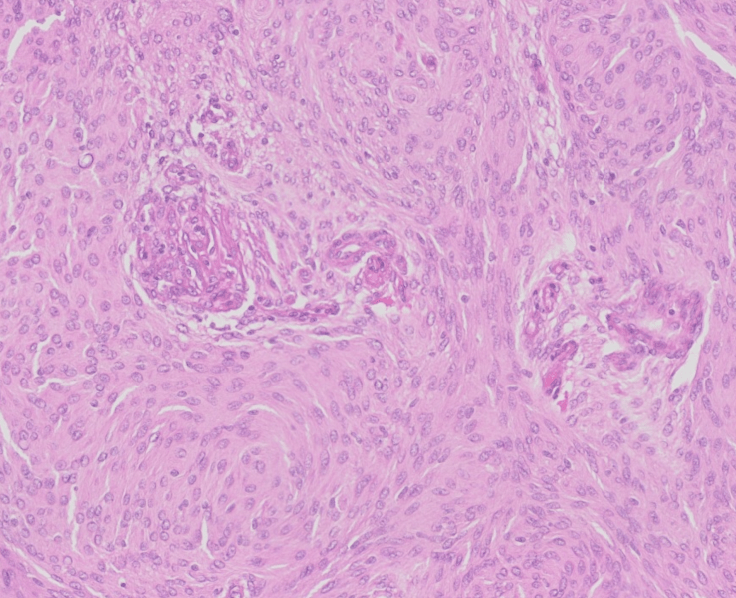
Mengioma_ vascular changes and prognosis

Meningiomas, like the one pictured here, typically show whorling architectural pattern and nuclear pseduoinclusions. The vast majority of meningiomas are low grade (WHO Grade 1) dura-based tumors with good prognosis following complete resection. However, recent studies have suggested that endothelial cell hypertrophy and/or microvascular proliferation in an otherwise typical meningioma are correlated with shorter progression free survival.
For further study on this topic and others related to neuropathology and neuroanatomy, the following books come highly recommended:

Leave a comment